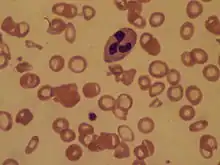

Iron-deficiency anemia
| Iron-deficiency anemia | |
|---|---|
| Other names | Iron-deficiency anaemia,
FeDA, Sideropenic Anemia |
![]() | |
| Red blood cells | |
| Specialty | Hematology |
| Symptoms | Feeling tired, weakness, shortness of breath, confusion, pallor[1] |
| Complications | Heart failure, arrhythmias, frequent infections[2] |
| Causes | Iron deficiency[3] |
| Diagnostic method | Blood tests[4] |
| Treatment | Dietary changes, medications, surgery[3] |
| Medication | Iron supplements, vitamin C, blood transfusions[5] |
| Frequency | 1.48 billion (2015)[6] |
| Deaths | 54,200 (2015)[7] |
Iron-deficiency anemia is anemia caused by a lack of iron.[3] Anemia is defined as a decrease in the number of red blood cells or the amount of hemoglobin in the blood.[3] When onset is slow, symptoms are often vague such as feeling tired, weak, short of breath, or having decreased ability to exercise.[1] Anemia that comes on quickly often has more severe symptoms, including confusion, feeling like one is going to pass out or increased thirst.[1] Anemia is typically significant before a person becomes noticeably pale.[1] Children with iron deficiency anemia may have problems with growth and development.[3] There may be additional symptoms depending on the underlying cause.[1]
Iron-deficiency anemia is caused by blood loss, insufficient dietary intake, or poor absorption of iron from food.[3] Sources of blood loss can include heavy periods, childbirth, uterine fibroids, stomach ulcers, colon cancer, and urinary tract bleeding.[8] Poor absorption of iron from food may occur as a result of an intestinal disorder such as inflammatory bowel disease or celiac disease, or surgery such as a gastric bypass.[8] In the developing world, parasitic worms, malaria, and HIV/AIDS increase the risk of iron deficiency anemia.[9] Diagnosis is confirmed by blood tests.[4]
Iron deficiency anemia can be prevented by eating a diet containing sufficient amounts of iron or by iron supplementation.[10] Foods high in iron include meat, nuts, and foods made with iron-fortified flour.[11] Treatment may include dietary changes, iron supplements, and dealing with underlying causes, for example medical treatment for parasites or surgery for ulcers.[3] Supplementation with vitamin C may be recommended due to its potential to aid iron absorption.[5] Severe cases may be treated with blood transfusions or iron infusions.[3]
Iron-deficiency anemia affected about 1.48 billion people in 2015.[6] A lack of dietary iron is estimated to cause approximately half of all anemia cases globally.[12] Women and young children are most commonly affected.[3] In 2015, anemia due to iron deficiency resulted in about 54,000 deaths – down from 213,000 deaths in 1990.[7][13]
Signs and symptoms
Iron-deficiency anemia may be present without a person experiencing symptoms.[14] It tends to develop slowly; therefore the body has time to adapt, and the disease often goes unrecognized for some time.[15] If symptoms present, patients may present with the sign of pallor (reduced oxyhemoglobin in skin or mucous membranes),[16] and the symptoms of feeling tired, weak, dizziness, lightheadedness, poor physical exertion, headaches, decreased ability to concentrate, cold hands and feet, cold sensitivity, increased thirst and confusion.[14][16] None of these symptoms (or any of the others below) are sensitive or specific.
In severe cases, shortness of breath can occur.[17] Pica may also develop; of which consumption of ice, known as pagophagia, has been suggested to be the most specific for iron deficiency anemia.[15]
Other possible symptoms and signs of iron-deficiency anemia include:[3][15][17][18]

- Irritability
- Angina (chest pain)
- Palpitations (feeling that the heart is skipping beats or fluttering)
- Breathlessness
- Tingling, numbness, or burning sensations
- Glossitis (inflammation or infection of the tongue)
- Angular cheilitis (inflammatory lesions at the mouth's corners)
- Koilonychia (spoon-shaped nails) or nails that are brittle
- Poor appetite
- Dysphagia (difficulty swallowing) due to formation of esophageal webs (Plummer–Vinson syndrome)
- Periorbital hyperpigmentation (darkening of the skin around the eyes), the cause is unknown and assumed to be related to the iron-deficiency induced worse blood oxygenation and vitamin B12[19]
- Restless legs syndrome[20]
Child development
Iron-deficiency anemia is associated with poor neurological development, including decreased learning ability and altered motor functions.[21][22] This is because iron deficiency impacts the development of the cells of the brain called neurons. When the body is low on iron, the red blood cells get priority on iron, and it is shifted away from the neurons of the brain. Exact causation has not been established, but there is a possible long-term impact from these neurological issues.[22]
Cause
A diagnosis of iron-deficiency anemia requires further investigation into its cause.[23] It can be caused by increased iron demand, increased iron loss, or decreased iron intake.[24] Increased iron demand often occurs during periods of growth, such as in children and pregnant women.[25] For example, during stages of rapid growth, babies and adolescents may outpace their dietary intake of iron which can result in deficiency in the absence of disease or a grossly abnormal diet.[24] Iron loss is typically from blood loss.[25] One example of blood loss is by chronic gastrointestinal blood loss, which could be linked to a possible cancer.[23] In women of childbearing age, heavy menstrual periods can be a source of blood loss causing iron-deficiency anemia.[23] People who do not consume much iron in their diet, such as vegans or vegetarians, are also at increased risk of developing iron deficiency anemia.[14]
Parasitic disease
The leading cause of iron-deficiency anemia worldwide is a parasitic disease known as a helminthiasis caused by infestation with parasitic worms (helminths); specifically, hookworms. The hookworms most commonly responsible for causing iron-deficiency anemia include Ancylostoma duodenale, Ancylostoma ceylanicum, and Necator americanus.[23][26] The World Health Organization estimates that approximately two billion people are infected with soil-transmitted helminths worldwide.[27] Parasitic worms cause both inflammation and chronic blood loss by binding to a human's small-intestinal mucosa, and through their means of feeding and degradation, they can ultimately cause iron-deficiency anemia.[15][26]
Blood loss
Red blood cells contain iron, so blood loss also leads to iron loss. There are several causes of blood loss, including menstrual bleeding, gastrointestinal bleeding, stomach ulcers, and bleeding disorders.[28] The bleeding may occur quickly or slowly. Slow, chronic blood loss within the body – such as from a peptic ulcer, angiodysplasia, inflammatory bowel disease, a colon polyp or gastrointestinal cancer (e.g., colon cancer) – can cause iron-deficiency anemia.[29]
Menstrual bleeding
Menstrual bleeding is a common cause of iron deficiency anemia in women of childbearing age.[28] Women with menorrhagia (heavy menstrual periods) are at risk of iron deficiency anemia because they are at higher than normal risk of losing more iron during menstruation than is replaced in their diet. Most women lose about 40 mL of blood per cycle. Some birth control methods, such as pills and IUDs, may decrease the amount of blood and therefore iron lost during a menstrual cycle.[28] Intermittent iron supplementation may be as effective a treatment in these cases as daily supplements and reduce some of the adverse effects of long-term daily supplements.[30]
Gastrointestinal bleeding
The most common cause of iron deficiency anemia in men and post-menopausal women is gastrointestinal bleeding.[28] There are many sources of gastrointestinal tract bleeding, including the stomach, esophagus, small intestine, and the large intestine (colon). Gastrointestinal bleeding can result from regular use of some medications, such as non-steroidal anti-inflammatory drugs (e.g. aspirin), as well as antiplatelets such as clopidogrel and anticoagulants such as warfarin; however, these are required in some patients, especially those with states causing a tendency to form blood clots. Colon cancer, which typically occurs in older individuals, is another potential cause of gastrointestinal bleeding.[31] In addition, some bleeding disorders, such as von Willebrand disease and polycythemia vera, can cause gastrointestinal bleeding.[28]
Blood donation
Frequent blood donors are also at risk for developing iron deficiency anemia.[32] When whole blood is donated, approximately 200 mg of iron is lost from the body.[28] The blood bank screens people for anemia before drawing blood for donation. If the patient has anemia, blood is not drawn.[28] Less iron is lost if the person is donating platelets or white blood cells.[28]
Diet

The body normally gets the iron it requires from food. If a person consumes too little iron, or iron that is poorly absorbed (non-heme iron), they can become iron deficient over time. Examples of iron-rich foods include meat, eggs, leafy green vegetables and iron-fortified foods. For proper growth and development, infants and children need dietary iron.[34] For children, a high intake of cow's milk is associated with an increased risk of iron-deficiency anemia.[35] Other risk factors include low meat intake and low intake of iron-fortified products.[35]
The National Academy of Medicine updated Estimated Average Requirements (EAR) and Recommended Dietary Allowances (RDA) in 2001. The current EAR for iron for women ages 14–18 is 7.9 mg/day, 8.1 for ages 19–50, and 5.0 thereafter (post menopause). For men the EAR is 6.0 mg/day for ages 19 and up. The RDA is 15.0 mg/day for women ages 15–18, 18.0 for 19–50, and 8.0 thereafter; for men, 8.0 mg/day for ages 19 and up. (Recommended Dietary Allowances are higher than Estimated Average Requirements so as to cover people with higher than average requirements.) The RDA for pregnancy is 27 mg/day, and during lactation, 9 mg/day. For children ages 1–3 years it is 7 mg/day, 10 for ages 4–8 and 8 for ages 9–13.[36] The European Food Safety Authority refers to the collective set of information as Dietary Reference Values, with Population Reference Intakes instead of RDAs, and Average Requirements instead of EARs. For women the Population Reference Intake is 13 mg/day ages 15–17 years, 16 mg/day for women ages 18 and up who are premenopausal, and 11 mg/day postmenopausal; for pregnancy and lactation, 16 mg/day. For men the Population Reference Intake is 11 mg/day ages 15 and older. For children ages 1 to 14 the Population Reference Intake increases from 7 to 11 mg/day. The Population Reference Intakes are higher than the US RDAs, with the exception of pregnancy.[37]
Iron malabsorption
Iron from food is absorbed into the bloodstream in the small intestine, primarily in the duodenum.[38] Iron malabsorption is a less common cause of iron-deficiency anemia, but many gastrointestinal disorders can reduce the body's ability to absorb iron.[39] There are different mechanisms that may be present.
In coeliac disease, abnormal changes in the structure of the duodenum can decrease iron absorption.[40] Abnormalities or surgical removal of the stomach can also lead to malabsorption by altering the acidic environment needed for iron to be converted into its absorbable form.[39] If there is insufficient production of hydrochloric acid in the stomach, hypochlorhydria/achlorhydria can occur (often due to chronic H. pylori infections or long-term proton-pump inhibitor therapy), inhibiting the conversion of ferric iron to the absorbable ferrous iron.[40]
Bariatric surgery is associated with an increased risk of iron deficiency anemia due to malabsorption of iron.[41] During a Roux-en-Y anastamosis, which is commonly performed for weight management and diabetes control, the stomach is made into a small pouch and this is connected directly to the small intestines further downstream (bypassing the duodenum as a site of digestion). About 17–45% of people develop iron deficiency after a Roux-en-Y gastric bypass.[42]
Pregnant women
Without iron supplementation, iron-deficiency anemia occurs in many pregnant women because their iron stores need to serve their own increased blood volume and be a source of hemoglobin for the growing baby and placental development.[34] Other less common causes are intravascular hemolysis and hemoglobinuria. Iron deficiency in pregnancy appears to cause long-term and irreversible cognitive problems in the baby.[43]
Iron deficiency affects maternal well-being by increasing risks for infections and complications during pregnancy.[44] Some of these complications include pre-eclampsia, bleeding problems, and perinatal infections.[44] Iron deficiency can lead to improper development of fetal tissues.[45] Oral iron supplementation during the early stages of pregnancy, specifically the first trimester, is suggested to decrease the adverse effects of iron-deficiency anemia throughout pregnancy and to decrease the negative impact that iron deficiency has on fetal growth.[44] Iron supplements may lead to a risk for gestational diabetes, so pregnant women with adequate hemoglobin levels are recommended not to take iron supplements.[46] Iron deficiency can lead to premature labor and to problems with neural functioning, including delays in language and motor development in the infant.[44]
Some studies show that women pregnant during their teenage years can be at greater risk of iron-deficiency anemia due to an already increased need for iron and other nutrients during adolescent growth spurts.[44]
Children
Babies are at increased risk of developing iron deficiency anemia due to their rapid growth.[25] Their need for iron is greater than they are getting in their diet.[25] Babies are born with iron stores; however, these iron stores typically run out by 4–6 months of age. In addition, infants who are given cow's milk too early can develop anemia due to gastrointestinal blood loss.[25]
Children who are at risk for iron-deficiency anemia include:[47]
- Preterm infants
- Low birth weight infants
- Infants fed with cow's milk under 12 months of age
- Breastfed infants who have not received iron supplementation after age 6 months, or those receiving non-iron-fortified formulas
- Children between the ages of 1 and 5 years old who receive more than 24 ounces (700 mL) of cow milk per day
- Children with low socioeconomic status
- Children with special health care needs
- Children of Hispanic ethnicity[48]
- Children who are overweight[48]
Hepcidin
Decreased levels of serum and urine hepcidin are early indicators of iron deficiency.[49] Hepcidin concentrations are also connected to the complex relationship between malaria and iron deficiency.[50]
Mechanism
Anemia can result from significant iron deficiency.[39] When the body has sufficient iron to meet its needs (functional iron), the remainder is stored for later use in cells, mostly in the bone marrow and liver.[39] These stores are called ferritin complexes and are part of the human (and other animals) iron metabolism systems. Men store about 3.5 g of iron in their body, and women store about 2.5 g.[14]
Hepcidin is a peptide hormone produced in the liver that is responsible for regulating iron levels in the body. Hepcidin decreases the amount of iron available for erythropoesis (red blood cell production).[41] Hepcidin binds to and induces the degradation of ferroportin, which is responsible for exporting iron from cells and mobilizing it to the bloodstream.[41] Conditions such as high levels of erythropoesis, iron deficiency and tissue hypoxia inhibit hepcidin expression.[41] Whereas systemic infection or inflammation (especially involving the cytokine IL-6) or increased circulating iron levels stimulate hepcidin expression.[41]
Iron is a mineral that is important in the formation of red blood cells in the body, particularly as a critical component of hemoglobin.[23] About 70% of the iron found in the body is bound to hemoglobin.[14] Iron is primarily absorbed in the small intestine, in particular the duodenum and jejunum. Certain factors increase or decrease absorption of iron. For example, taking Vitamin C with a source of iron is known to increase absorption. Some medications such as tetracyclines and antacids can decrease absorption of iron.[14] After being absorbed in the small intestine, iron travels through blood, bound to transferrin, and eventually ends up in the bone marrow, where it is involved in red blood cell formation.[23] When red blood cells are degraded, the iron is recycled by the body and stored.[23]
When the amount of iron needed by the body exceeds the amount of iron that is readily available, the body can use iron stores (ferritin) for a period of time, and red blood cell formation continues normally.[39] However, as these stores continue to be used, iron is eventually depleted to the point that red blood cell formation is abnormal.[39] Ultimately, anemia ensues, which by definition is a hemoglobin lab value below normal limits.[3][39]
Diagnosis
Conventionally, a definitive diagnosis requires a demonstration of depleted body iron stores obtained by bone marrow aspiration, with the marrow stained for iron.[51][52] However, with the availability of reliable blood tests that can be more readily collected for iron-deficiency anemia diagnosis, a bone marrow aspiration is usually not obtained.[53] Furthermore, a study published in April 2009 questions the value of stainable bone marrow iron following parenteral iron therapy.[54] Once iron deficiency anemia is confirmed, gastrointestinal blood loss is presumed to be the cause until proven otherwise since it can be caused by an otherwise asymptomatic colon cancer. The initial evaluation must include esophagogastroduodenoscopy and colonoscopy to evaluate for cancer or bleeding of the gastrointestinal tract.[29]
A thorough medical history is important to the diagnosis of iron-deficiency anemia. The history can help to differentiate common causes of the condition such as menstruation in women or blood in the stool.[55] A travel history to areas in which hookworms and whipworms are endemic may also help guide certain stool tests for parasites or their eggs.[56] Although symptoms can play a role in identifying iron-deficiency anemia, they are often vague, which may limit their contribution to determining the diagnosis.
Blood tests
| Change | Parameter |
|---|---|
| ↓ | ferritin, hemoglobin, mean corpuscular volume, mean corpuscular hemoglobin |
| ↑ | total iron-binding capacity, transferrin, red blood cell distribution width |
Anemia is often discovered by routine blood tests. A sufficiently low hemoglobin by definition makes the diagnosis of anemia, and a low hematocrit value is also characteristic of anemia. Further studies will be undertaken to determine the anemia's cause. If the anemia is due to iron deficiency, one of the first abnormal values to be noted on a complete blood count, as the body's iron stores begin to be depleted, will be a high red blood cell distribution width, reflecting an increased variability in the size of red blood cells.[15][23]
A low mean corpuscular volume also appears during the course of body iron depletion. It indicates a high number of abnormally small red blood cells. A low mean corpuscular volume, a low mean corpuscular hemoglobin or mean corpuscular hemoglobin concentration, and the corresponding appearance of red blood cells on visual examination of a peripheral blood smear narrows the problem to a microcytic anemia (literally, a small red blood cell anemia).[15]
The blood smear of a person with iron-deficiency anemia shows many hypochromic (pale, relatively colorless) and small red blood cells, and may also show poikilocytosis (variation in shape) and anisocytosis (variation in size).[15][53] With more severe iron-deficiency anemia, the peripheral blood smear may show hypochromic, pencil-shaped cells and, occasionally, small numbers of nucleated red blood cells.[57] The platelet count may be slightly above the high limit of normal in iron-deficiency anemia (termed a mild thrombocytosis), but severe cases can present with thrombocytopenia (low platelet count).[58]
Iron-deficiency anemia is confirmed by tests that include serum ferritin, serum iron level, serum transferrin, and total iron binding capacity.[59] A low serum ferritin is most commonly found. However, serum ferritin can be elevated by any type of chronic inflammation and thus is not consistently decreased in iron-deficiency anemia.[23] Serum iron levels may be measured, but serum iron concentration is not as reliable as the measurement of both serum iron and serum iron-binding protein levels.[18] The percentage of iron saturation (or transferrin saturation index or percent) can be measured by dividing the level of serum iron by total iron binding capacity and is a value that can help to confirm the diagnosis of iron-deficiency anemia; however, other conditions must also be considered, including other types of anemia.[18]
Another finding that can be used is the level of red blood cell distribution width.[60] During haemoglobin synthesis, trace amounts of zinc will be incorporated into protoporphyrin in the place of iron which is lacking. Protoporphyrin can be separated from its zinc moiety and measured as free erythrocyte protoporphyrin, providing an indirect measurement of the zinc-protoporphyrin complex. The level of free erythrocyte protoporphyrin is expressed in either μg/dl of whole blood or μg/dl of red blood cells. An iron insufficiency in the bone marrow can be detected very early by a rise in free erythrocyte protoporphyrin.
Further testing may be necessary to differentiate iron-deficiency anemia from other disorders, such as thalassemia minor.[61] It is very important not to treat people with thalassemia with an iron supplement, as this can lead to hemochromatosis. A hemoglobin electrophoresis provides useful evidence for distinguishing these two conditions, along with iron studies.[18][62]
Screening
It is unclear if screening pregnant women for iron-deficiency anemia during pregnancy improves outcomes in the United States.[63] The same holds true for screening children who are 6 to 24 months old.[64] Even so, screening is a Level B recommendation suggested by the US Preventative Services Task Force in pregnant women without symptoms and in infants considered high risk. Screening is done with either a hemoglobin or hematocrit lab test.[48]
Treatment

Treatment should take into account the cause and severity of the condition.[5] If the iron-deficiency anemia is a result of blood loss or another underlying cause, treatment is geared toward addressing the underlying cause.[5] Most cases of iron deficiency anemia are treated with oral iron supplements.[65] In severe acute cases, treatment measures are taken for immediate management in the interim, such as blood transfusions or intravenous iron.[5]
For less severe cases, treatment of iron-deficiency anemia includes dietary changes to incorporate iron-rich foods into regular oral intake and oral iron supplementation.[5] Foods rich in ascorbic acid (vitamin C) can also be beneficial, since ascorbic acid enhances iron absorption.[5] Oral iron supplements are available in multiple forms. Some are in the form of pills and some are drops for children.[5]
Most forms of oral iron replacement therapy are absorbed well by the small intestine; however, there are certain preparations of iron supplements that are designed for longer release in the small intestine than other preparations.[65] Oral iron supplements are best taken up by the body on an empty stomach because food can decrease the amount of iron absorbed from the small intestine.[65] The dosing of oral iron replacement therapy is as much as 100–200 mg per day in adults and 3–6 mg per kilogram in children.[41] This is generally spread out as 3–4 pills taken throughout the day.[65]
The various forms of treatment are not without possible adverse side effects. Iron supplementation by mouth commonly causes negative gastrointestinal effects, including constipation, nausea, vomiting, metallic taste to the oral iron and dark colored stools.[66][41] Constipation is reported by 15–20% of patients taking oral iron therapy.[65] Preparations of iron therapy that take longer to be absorbed by the small intestine (extended release iron therapy) are less likely to cause constipation.[65]
It can take six months to one year to get blood levels of iron up to a normal range and provide the body with iron stores.[65] Oral iron replacement may not be effective in cases of iron deficiency due to malabsorption, such as celiac disease, inflammatory bowel disease, or H. pylori infection; these cases would require treatment of the underlying disease to increase oral absorption or intravenous iron replacement.[41]
As iron-deficiency anemia becomes more severe, if the anemia does not respond to oral treatments, or if the treated person does not tolerate oral iron supplementation, then other measures may become necessary.[5][66] Two options are intravenous iron injections and blood transfusion.[65] Intravenous can be for people who do not tolerate oral iron, who are unlikely to respond to oral iron, or who require iron on a long-term basis.[65] For example, people receiving dialysis treatment who are also getting erythropoietin or another erythropoiesis-stimulating agent are given parenteral iron, which helps the body respond to the erythropoietin agents to produce red blood cells.[66][67][41]
Intravenous iron can induce an allergic response that can be as serious as anaphylaxis, although different formulations have decreased the likelihood of this adverse effect.[66] In certain cases intravenous iron is both safer and more effective than the oral route.[68] For patients with severe anemia such as from blood loss, or who have severe symptoms such as cardiovascular instability, a blood transfusion may be considered.[65]
Low-certainty evidence suggests that IBD-related anemia treatment with Intravenous (IV) iron infusion may be more effective than oral iron therapy, with fewer people needing to stop treatment early due to adverse effects. [69] The type of iron preparation may be an important determinant of clinical benefit. Moderate-certainty evidence suggests response to treatment may be higher when IV ferric carboxymaltose, rather than IV iron sucrose preparation is used, despite very-low certainty evidence of increased adverse effects, including bleeding, in those receiving ferric carboxymaltose treatment. [69]
Ferric maltol, marketed as Accrufer and Ferracru, is available in oral and IV preparations. When used as a treatment for IBD-related anemia, very low certainty evidence suggests a marked benefit with oral ferric maltol compared with placebo. However it was unclear whether the IV preparation was more effective than oral ferric maltol. [70]
A Cochrane review of controlled trials comparing intravenous (IV) iron therapy with oral iron supplements in people with chronic kidney disease, found low-certainty evidence that people receiving IV-iron treatment were 1.71 times as likely to reach their target hemoglobin levels.[71] Overall, hemoglobin was 0.71g/dl higher than those treated with oral iron supplements. Iron stores in the liver, estimated by serum ferritin, were also 224.84 μg/L higher in those receiving IV-iron.[71] However there was also low-certainty evidence that allergic reactions were more likely following IV-iron therapy. It was unclear whether type of iron therapy administration affects the risk of death from any cause, including cardiovascular, nor whether it may alter the number of people who may require a blood transfusion or dialysis.[71]
Ferric derisomaltose (Monoferric) was approved in the United States in January 2020, for the treatment of iron deficiency anemia.[72][73]
Epidemiology


A moderate degree of iron-deficiency anemia affects approximately 610 million people worldwide or 8.8% of the population.[75] It is slightly more common in females (9.9%) than males (7.8%).[75] Up to 15% of children ages 1–3 years have iron deficiency anemia.[48] Mild iron deficiency anemia affects another 375 million.[75] Iron deficiency affects up to 52% of pregnant women worldwide.[44]
The prevalence of iron deficiency as a cause of anemia varies among countries; in the groups in which anemia is most common, including young children and a subset of non-pregnant women, iron deficiency accounts for a fraction of anemia cases in these groups (25% and 37%, respectively).[76] Iron deficiency is common in pregnant women.[77]
Within the United States, iron-deficiency anemia affects about 2% of adult males, 10.5% of White women, and 20% of African-American and Mexican-American women.[78] A new study in 2024 suggests that nearly 1 in 3 Americans may have undiagnosed iron deficiency, which can cause fatigue, brain fog, and concentration problems. The analysis of data from over 8,000 U.S. adults found that 14% had low iron levels, known as absolute iron deficiency, while 15% had normal iron levels but their bodies couldn’t effectively use the mineral, a condition called functional iron deficiency.[79]
A map provides a country-by-country listing of what nutrients are fortified into specified foods. Some of the Sub-Saharan countries shown in the deaths from iron-deficiency anemia map from 2012 are as of 2018 fortifying foods with iron.[33]
References
- 1 2 3 4 5 Janz TG, Johnson RL, Rubenstein SD (November 2013). "Anemia in the emergency department: evaluation and treatment". Emergency Medicine Practice. 15 (11): 1–15, quiz 15–6. PMID 24716235.
- ↑ "What Are the Signs and Symptoms of Iron-Deficiency Anemia?". NHLBI. 26 March 2014. Archived from the original on 5 July 2017. Retrieved 17 July 2017.
- 1 2 3 4 5 6 7 8 9 10 11 "What Is Iron-Deficiency Anemia? – NHLBI, NIH". www.nhlbi.nih.gov. 26 March 2014. Archived from the original on 16 July 2017. Retrieved 17 July 2017.
- 1 2 "How Is Iron-Deficiency Anemia Diagnosed?". NHLBI. 26 March 2014. Archived from the original on 15 July 2017. Retrieved 17 July 2017.
- 1 2 3 4 5 6 7 8 9 "How Is Iron-Deficiency Anemia Treated?". NHLBI. 26 March 2014. Archived from the original on 28 July 2017. Retrieved 17 July 2017.
- 1 2 Vos T, Allen C, Arora M, Barber RM, Bhutta ZA, Brown A, et al. (GBD 2015 Disease and Injury Incidence and Prevalence Collaborators) (October 2016). "Global, regional, and national incidence, prevalence, and years lived with disability for 310 diseases and injuries, 1990–2015: a systematic analysis for the Global Burden of Disease Study 2015". Lancet. 388 (10053): 1545–1602. doi:10.1016/S0140-6736(16)31678-6. PMC 5055577. PMID 27733282.
- 1 2 Wang H, Naghavi M, Allen C, Barber RM, Bhutta ZA, Carter A, et al. (GBD 2015 Mortality and Causes of Death Collaborators) (October 2016). "Global, regional, and national life expectancy, all-cause mortality, and cause-specific mortality for 249 causes of death, 1980–2015: a systematic analysis for the Global Burden of Disease Study 2015". Lancet. 388 (10053): 1459–1544. doi:10.1016/s0140-6736(16)31012-1. PMC 5388903. PMID 27733281.
- 1 2 "What Causes Iron-Deficiency Anemia?". NHLBI. 26 March 2014. Archived from the original on 14 July 2017. Retrieved 17 July 2017.
- ↑ "Micronutrient deficiencies". World Health Organization (WHO). Archived from the original on 13 July 2017. Retrieved 17 July 2017.
- ↑ "How Can Iron-Deficiency Anemia Be Prevented?". NHLBI. 26 March 2014. Archived from the original on 28 July 2017. Retrieved 17 July 2017.
- ↑ "Iron". Office of Dietary Supplements. Retrieved 11 December 2018.
- ↑ Combs GF (2012). The Vitamins. Academic Press. p. 477. ISBN 978-0-12-381980-2.
- ↑ Naghavi M, Wang H, Lozano R, Davis A, Liang X, Zhou M, et al. (GBD 2013 Mortality and Causes of Death Collaborators) (January 2015). "Global, regional, and national age-sex specific all-cause and cause-specific mortality for 240 causes of death, 1990–2013: a systematic analysis for the Global Burden of Disease Study 2013". Lancet. 385 (9963): 117–71. doi:10.1016/S0140-6736(14)61682-2. PMC 4340604. PMID 25530442.
- 1 2 3 4 5 6 Bope ET, Kellerman RD (2018). Conn's Current Therapy. Philadelphia: Elsevier. pp. 403–405.
- 1 2 3 4 5 6 7 Goldman L, Schafer A (2016). Goldman-Cecil Medicine. Elsevier/Saunders. pp. 1052–1059, 1068–1073, 2159–2164. ISBN 978-1-4557-5017-7.
- 1 2 "What Is Iron Deficiency Anemia?". WebMD. Retrieved 2021-12-02.
- 1 2 Ferri F (2018). Ferri's Clinical Advisor 2018. Elsevier. pp. 87–88, e1 – e3713. ISBN 978-0-323-28049-5.
- 1 2 3 4 McPherson R, Pincus M (2017). Henry's Clinical Diagnosis and Management by Laboratory Methods. Elsevier. pp. 84–101, 559–605. ISBN 978-0-323-29568-0.
- ↑ Mendiratta V, Rana S, Jassi R, Chander R (Jun 2019). "Study of Causative Factors and Clinical Patterns of Periorbital Pigmentation". Indian Dermatol Online J. 10 (3): 293–295. doi:10.4103/idoj.IDOJ_158_18. PMC 6536080. PMID 31149574.
- ↑ Rangarajan S, D'Souza GA (April 2007). "Restless legs syndrome in Indian patients having iron deficiency anemia in a tertiary care hospital". Sleep Medicine. 8 (3): 247–51. doi:10.1016/j.sleep.2006.10.004. PMID 17368978.
- ↑ Kliegman R, Stanton B, St Geme J, Schor N (2016). Nelson Textbook of Pediatrics. Elsevier Health Sciences. pp. 2323–2326. ISBN 978-1-4557-7566-8.
- 1 2 Polin R, Ditmar M (2016). Pediatric Secrets. Elsevier. pp. 296–340. ISBN 978-0-323-31030-7.
- 1 2 3 4 5 6 7 8 9 Howard M, Hamilton P (2013). Haematology: An Illustrated Colour Text. Elsevier. pp. 24–25. ISBN 978-0-7020-5139-5.
- 1 2 Baird-Gunning J, Bromley J (December 2016). "Correcting iron deficiency". Australian Prescriber. 39 (6): 193–199. doi:10.18773/austprescr.2016.069. PMC 5155066. PMID 27990046.
- 1 2 3 4 5 M. Tarek Elghetany, Katherine I. Schexneider and Katalin Banki (2017). Henry's Clinical Diagnosis and Management by Laboratory Methods. Elsevier. pp. 559–605.
- 1 2 Broaddus VC, Mason R, Ernst J, et al. (2016). Murray and Nadel's Textbook of Respiratory Medicine. Elsevier Saunders. pp. 682–698. ISBN 978-1-4557-3383-5.
- ↑ "Soil-transmitted helminth infections". Archived from the original on 2014-02-21. Retrieved 2014-03-05. World Health Organization Fact Sheet No. 366, Soil-Transmitted Helminth Infections, updated June 2013
- 1 2 3 4 5 6 7 8 Ganz T (2016). "Iron Deficiency and Overload". In Kaushansky K, Lichtman MA, Prchal JT, Levi MM, Press OW, Burns LJ, Caligiuri M (eds.). Williams Hematology (9th ed.). New York, NY: McGraw Hill. ISBN 978-0-07-183301-1.
- 1 2 Rockey DC, Altayar O, Falck-Ytter Y, Kalmaz D (September 2020). "AGA Technical Review on Gastrointestinal Evaluation of Iron Deficiency Anemia". Gastroenterology. 159 (3): 1097–1119. doi:10.1053/j.gastro.2020.06.045. PMC 10824166. PMID 32828801.
- ↑ Fernández-Gaxiola AC, De-Regil LM (31 January 2019). "Intermittent iron supplementation for reducing anaemia and its associated impairments in adolescent and adult menstruating women". The Cochrane Database of Systematic Reviews. 1 (5): CD009218. doi:10.1002/14651858.CD009218.pub3. ISSN 1469-493X. PMC 6360921. PMID 30699468.
- ↑ "Colon cancer – Symptoms and causes". Mayo Clinic. Retrieved 2018-12-13.
- ↑ Adamson JW, Jameson J, Fauci AS, Kasper DL, Hauser SL, Longo DL, Loscalzo J (2005). Harrison's Principles of Internal Medicine (20th ed.). New York, NY: McGraw-Hill.
- 1 2 "Map: Count of Nutrients In Fortification Standards". Food Fortification Initiative. 29 October 2018. Retrieved 12 December 2018.
- 1 2 "Iron deficiency anemia". Mayo Clinic. March 4, 2011. Archived from the original on November 27, 2012. Retrieved December 11, 2012.
- 1 2 Decsi T, Lohner S (2014). "Gaps in meeting nutrient needs in healthy toddlers". Annals of Nutrition & Metabolism. 65 (1): 22–8. doi:10.1159/000365795. PMID 25227596. S2CID 23683533.
- ↑ Institute of Medicine (US) Panel on Micronutrients (2001). "Iron" (PDF). Dietary Reference Intakes for Vitamin A, Vitamin K, Arsenic, Boron, Chromium, Copper, Iodine, Iron, Manganese, Molybdenum, Nickel, Silicon, Vanadium, and Iron. National Academy Press. pp. 290–393. ISBN 978-0-309-07279-3. PMID 25057538. Archived from the original (PDF) on 2017-09-09. Retrieved 2018-12-07.
- ↑ "Overview on Dietary Reference Values for the EU population as derived by the EFSA Panel on Dietetic Products, Nutrition and Allergies" (PDF). European Food Safety Authority. 2017.
- ↑ Yeo C (2013). Shackelford's Surgery of the Alimentary Tract. pp. 821–838. ISBN 978-1-4377-2206-2.
- 1 2 3 4 5 6 7 Porwit A, McCullough J, Erber W (2011). Blood and Bone Marrow Pathology. Churchill Livingstone. pp. 173–195. ISBN 978-0-7020-3147-2.
- 1 2 Feldman M, Friedman L, Brandt L (2016). Sleisenger and Fordtran's Gastrointestinal and Liver Disease. Elsevier Saunders. pp. 297–335. ISBN 978-1-4557-4692-7.
- 1 2 3 4 5 6 7 8 9 Longo DL, Camaschella C (7 May 2015). "Iron-Deficiency Anemia". New England Journal of Medicine. 372 (19): 1832–1843. doi:10.1056/NEJMra1401038. PMID 25946282. S2CID 17628280.
- ↑ Stein J, Stier C, Raab H, Weiner R (September 2014). "Review article: the nutritional and pharmacological consequences of obesity surgery". Alimentary Pharmacology & Therapeutics. 40 (6): 582–609. doi:10.1111/apt.12872. PMID 25078533. S2CID 41444849.
- ↑ Lozoff B (December 2007). "Iron deficiency and child development". Food and Nutrition Bulletin. 28 (4 Suppl): S560-71. doi:10.1177/15648265070284S409. PMID 18297894. S2CID 31142805.
- 1 2 3 4 5 6 Abu-Ouf NM, Jan MM (February 2015). "The impact of maternal iron deficiency and iron deficiency anemia on child's health". Saudi Medical Journal. 36 (2): 146–9. doi:10.15537/smj.2015.2.10289. PMC 4375689. PMID 25719576.
- ↑ Miller JL (July 2013). "Iron deficiency anemia: a common and curable disease". Cold Spring Harbor Perspectives in Medicine. 3 (7): a011866. doi:10.1101/cshperspect.a011866. PMC 3685880. PMID 23613366.
- ↑ Si S, Shen Y, Xin X, Mo M, Shao B, Wang S, Luo W, Chen Z, Liu H, Chen D, Yu Y (2021). "Hemoglobin concentration and iron supplement during pregnancy were associated with an increased risk of gestational diabetes mellitus". Journal of Diabetes. 13 (3): 211–221. doi:10.1111/1753-0407.13101. ISSN 1753-0407. PMID 32755052. S2CID 220976197.
- ↑ McInerny TK (2017). American Academy of Pediatrics textbook of pediatric care (2nd ed.). Elk Grove Village, IL: American Academy of Pediatrics. ISBN 978-1-61002-047-3. OCLC 952123506.
- 1 2 3 4 Primack BA, Mahaniah KJ. Anemia. In: South-Paul JE, Matheny SC, Lewis EL. eds. CURRENT Diagnosis & Treatment: Family Medicine, 4e New York, NY: McGraw-Hill; . Accessed November 30, 2018.
- ↑ D'Angelo G (March 2013). "Role of hepcidin in the pathophysiology and diagnosis of anemia". Blood Research. 48 (1): 10–5. doi:10.5045/br.2013.48.1.10. PMC 3624997. PMID 23589789.
- ↑ Chaparro CM, Suchdev PS (August 2019). "Anemia epidemiology, pathophysiology, and etiology in low- and middle-income countries". Annals of the New York Academy of Sciences. 1450 (1): 15–31. Bibcode:2019NYASA1450...15C. doi:10.1111/nyas.14092. PMC 6697587. PMID 31008520.
- ↑ Mazza J, Barr RM, McDonald JW, Valberg LS (October 1978). "Usefulness of the serum ferritin concentration in the detection of iron deficiency in a general hospital". Canadian Medical Association Journal. 119 (8): 884–6. PMC 1819106. PMID 737638. Archived from the original on 8 May 2009.
- ↑ Kis AM, Carnes M (July 1998). "Detecting iron deficiency in anemic patients with concomitant medical problems". Journal of General Internal Medicine. 13 (7): 455–61. doi:10.1046/j.1525-1497.1998.00134.x. PMC 1496985. PMID 9686711.
- 1 2 Kellerman R, Bope E (2018). Conn's Current Therapy 2018. Elsevier. pp. 403–405. ISBN 978-0-323-52769-9.
- ↑ Thomason RW, Almiski MS (April 2009). "Evidence that stainable bone marrow iron following parenteral iron therapy does not correlate with serum iron studies and may not represent readily available storage iron". American Journal of Clinical Pathology. 131 (4): 580–5. doi:10.1309/AJCPBAY9KRZF8NUC. PMID 19289594.
- ↑ Brady PG (October 2007). "Iron deficiency anemia: a call for aggressive diagnostic evaluation". Southern Medical Journal. 100 (10): 966–7. doi:10.1097/SMJ.0b013e3181520699. PMID 17943034.
- ↑ Bennett J, Dolin R, Blaser M (2015). Mandell, Douglas, and Bennett's Principles and Practice of Infectious Diseases, Updated Edition. Elsevier/Saunders. pp. 3196–3198. ISBN 978-0-323-40161-6.
- ↑ McPhee SJ, Papadakis MA (2009). Current Medical Diagnosis and Treatment. p. 428.
- ↑ Lanzkowsky P, Lipton J, Fish J (2016). Lanzkowsky's Manual of Pediatric Hematology and Oncology. Elsevier Science. pp. 69–83. ISBN 978-0-12-801368-7.
- ↑ Ivanova T, Klabukov I, Krikunova L, Poluektova MV, Sychenkova N, Khorokhorina V, Vorobyev N, Gaas M, Baranovskii D, Goryainova O, Sachko A, Shegay P, Kaprin A, Tillib S (2022). "Prognostic Value of Serum Transferrin Analysis in Patients with Ovarian Cancer and Cancer-Related Functional Iron Deficiency: A Retrospective Case-Control Study". Journal of Clinical Medicine. 11 (24): 7377. doi:10.3390/jcm11247377. ISSN 2077-0383. PMC 9786287. PMID 36555993.
- ↑ World Health Organization, Centers for Disease Control and Prevention. (2007). Technical consultation on the assessment of iron status at the population level. Assessing the iron status of populations: including literature reviews (second ed.). ISBN 978-92-4-159610-7. Archived from the original on March 19, 2014.
- ↑ O'Connell T (2017). Instant Work-ups: A Clinical Guide to Medicine. Philadelphia, PA: Elsevier. pp. 23–31. ISBN 978-0-323-37641-9.
- ↑ Hines R, Marschall K (2018). Stoelting's Anesthesia and Co-existing Disease. Elsevier. pp. 477–506. ISBN 978-0-323-40137-1.
- ↑ Siu AL (October 2015). "Screening for Iron Deficiency Anemia and Iron Supplementation in Pregnant Women to Improve Maternal Health and Birth Outcomes: U.S. Preventive Services Task Force Recommendation Statement". Annals of Internal Medicine. 163 (7): 529–36. doi:10.7326/m15-1707. PMID 26344176.
- ↑ Siu AL (October 2015). "Screening for Iron Deficiency Anemia in Young Children: USPSTF Recommendation Statement". Pediatrics. 136 (4): 746–52. doi:10.1542/peds.2015-2567. PMID 26347426.
- 1 2 3 4 5 6 7 8 9 10 Adamson JW (2014). Iron Deficiency and Other Hypoproliferative Anemias. In: Kasper D, Fauci A, Hauser S, Longo D, Jameson J, Loscalzo J. eds. Harrison's Principles of Internal Medicine, 19e New York, NY: McGraw-Hill.
- 1 2 3 4 Kasper D, Fauci A, Hauser S, Longo D, Jameson JL, Loscalzo J (2015). "126". Harrison's Principles of Internal Medicine (19th ed.). McGraw-Hill Education. ISBN 978-0-07-180215-4.
- ↑ "KDIGO clinical practice guideline for anemia in chronic kidney disease". Agency for Healthcare Research and Quality. August 2012. Archived from the original on 2017-12-07. Retrieved 2017-12-06.
- ↑ Auerbach M, Deloughery T (December 2016). "Single-dose intravenous iron for iron deficiency: a new paradigm". Hematology. American Society of Hematology. Education Program. 2016 (1): 57–66. doi:10.1182/asheducation-2016.1.57. PMC 6142502. PMID 27913463.
- 1 2 Gordon M, Sinopoulou V, Iheozor-Ejiofor Z, Iqbal T, Allen P, Hoque S, Engineer J, Akobeng AK (2021). "Interventions for treating iron deficiency anaemia in inflammatory bowel disease". Cochrane Database of Systematic Reviews. 1 (1): CD013529. doi:10.1002/14651858.CD013529.pub2. PMC 8092475. PMID 33471939.
- ↑ Gordon M, Sinopoulou V, Iheozor-Ejiofor Z, Iqbal T, Allen P, Hoque S, Engineer J, Akobeng AK (2021). "Interventions for treating iron deficiency anaemia in inflammatory bowel disease". Cochrane Database of Systematic Reviews. 1 (1): CD013529. doi:10.1002/14651858.CD013529.pub2. PMC 8092475. PMID 33471939.
- 1 2 3 O'Lone EL, Hodson EM, Nistor I, Bolignano D, Webster AC, Craig JC (2019). Cochrane Kidney and Transplant Group (ed.). "Parenteral versus oral iron therapy for adults and children with chronic kidney disease". Cochrane Database of Systematic Reviews. 2019 (2): CD007857. doi:10.1002/14651858.CD007857.pub3. PMC 6384096. PMID 30790278.
- ↑ "Drug Approval Package: Monoferric Injection". U.S. Food and Drug Administration (FDA). 7 May 2020. Retrieved 13 August 2020.
- ↑ "Monoferric- ferric derisomaltose solution". DailyMed. 24 January 2020. Retrieved 16 February 2020.
- ↑ "Mortality and Burden of Disease Estimates for WHO Member States in 2002" (xls). World Health Organization. 2002. Archived from the original on 2013-01-16.
- 1 2 3 Vos T, Flaxman AD, Naghavi M, Lozano R, Michaud C, Ezzati M, et al. (GBD 2013 Mortality and Causes of Death Collaborators) (December 2012). "Years lived with disability (YLDs) for 1160 sequelae of 289 diseases and injuries 1990–2010: a systematic analysis for the Global Burden of Disease Study 2010". Lancet. 380 (9859): 2163–96. doi:10.1016/S0140-6736(12)61729-2. PMC 6350784. PMID 23245607.
- ↑ Petry N, Olofin I, Hurrell RF, Boy E, Wirth JP, Moursi M, Donahue Angel M, Rohner F (November 2016). "The Proportion of Anemia Associated with Iron Deficiency in Low, Medium, and High Human Development Index Countries: A Systematic Analysis of National Surveys". Nutrients. 8 (11): 693. doi:10.3390/nu8110693. PMC 5133080. PMID 27827838.
- ↑ Sifakis S, Pharmakides G (2000). "Anemia in pregnancy". Annals of the New York Academy of Sciences. 900 (1): 125–36. Bibcode:2000NYASA.900..125S. doi:10.1111/j.1749-6632.2000.tb06223.x. PMID 10818399. S2CID 6740558.
- ↑ Killip S, Bennett JM, Chambers MD (March 2007). "Iron deficiency anemia". American Family Physician. 75 (5): 671–8. PMID 17375513. Archived from the original on 11 March 2016.
- ↑ Tawfik YM, Billingsley H, Bhatt AS, Aboelsaad I, Al-Khezi OS, Lutsey PL, Buckley LF (2024-09-24). "Absolute and Functional Iron Deficiency in the US, 2017-2020". JAMA Network Open. 7 (9): e2433126. doi:10.1001/jamanetworkopen.2024.33126. ISSN 2574-3805. PMC 11423176. PMID 39316402.
External links
- The Importance of Iron – From IronTherapy.Org
- Interactive material on Iron Metabolism Archived 2016-05-29 at the Wayback Machine – From IronAtlas.com
- Approach to chronic anemia : https://ashpublications.org/hematology/article/2012/1/183/83845/How-to-approach-chronic-anemia
- Handout: Iron Deficiency Anemia – From the National Anemia Action Council
- NPS News 70: Iron deficiency anaemia: NPS – Better choices, Better health – From the National Prescribing Service
